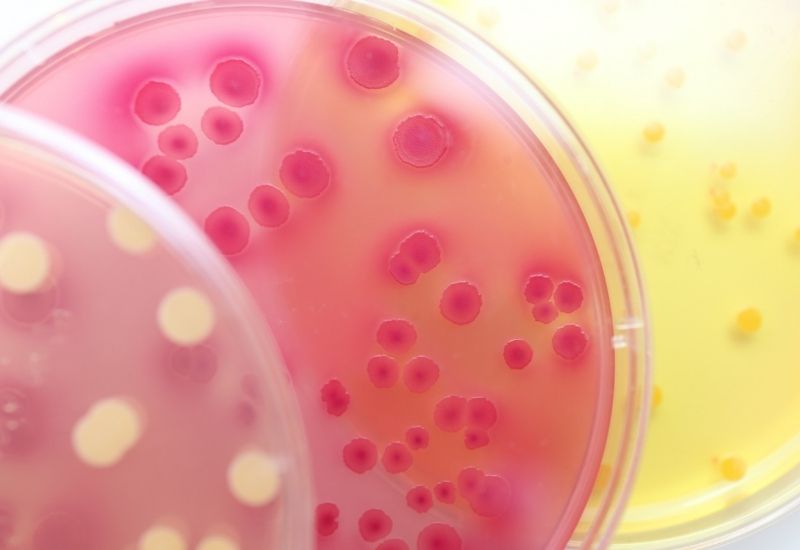
xét nghiệm atp

- Kỉ niệm 10 năm Thương hiệu Drip Hydrations | Nhận ưu đãi chỉ DÀNH RIÊNG cho Member DripClub!Tăng năng lượng - sống đỉnh cao với thẻ Vitamin Drip Membership.
HOTLINE: +84 90 1885 088
- Tận hưởng nhiều quyền lợi độc quyền, chỉ DÀNH RIÊNG cho Member DripClub! Chi tiết ➝Tăng năng lượng - sống đỉnh cao với thẻ Vitamin Drip Membership. Xem ngay ➝